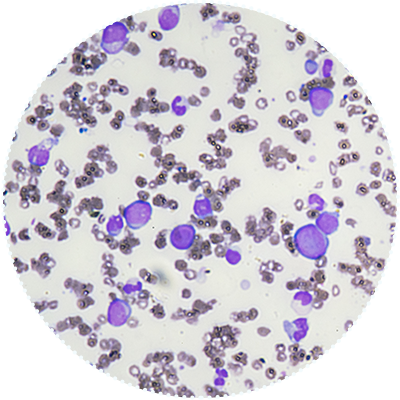

Advancing Cancer Research:



2600 B.C.
The Beginnings of Cancer Treatment
As early as 2600 B.C., Egyptian physician Imhotep used the body’s immune system to fight cancer by inducing an infection. According to the Ebers Papyrus, the recommended treatment for tumors was a poultice, which is a soft, moist mass of material that typically contains herbs and is placed on the skin to relieve soreness and inflammation. This was followed by an incision to facilitate the development of infection in the desired location and cause regression of the tumor.

Mid-18th Century
The Beginnings of Hematology
English surgeon and apothecary William Hewson, sometimes referred to as the “Father of Hematology,” publishes detailed studies that provide the basis of understanding on red and white blood cells. His findings show that fibrinogen – a protein in blood plasma – leads to coagulation and would eventually drive a greater understanding of the lymphatic system and inflammatory reactions"
1882
Radical Surgery to Remove Tumors
Following the invention of anesthesia, three surgeons, Dr. Theodor Billroth, Dr. William Halsted and Dr. William Handley, lead the charge in cancer operations to remove the entire tumor with lymph nodes. Dr. Billroth is considered a pioneer of gastric cancer surgery while Dr. Halsted introduces the first radical mastectomy for breast cancer, based on the work from Dr. William Handley, who believed cancer spread outward by invasion from the original growth. For the first half of the 20th century, surgery is the only option for cancer treatment.


1891
The Origins of Modern Immunotherapy: William B. Coley, M.D.
Dr. William B. Coley uses killed bacteria, called “Coley’s Toxins,” to stimulate an immune response to attack and shrink tumors in patients.
1898
Discovery of Radiation Therapy
Physicists Marie and Pierre Curie discover a chemical element known as radium, which is later shown to be an effective treatment for cancer in small doses. This discovery continues to serve as the basis of modern radiation treatment used today.


1898
Discovery of Radiation Therapy
Physicists Marie and Pierre Curie discover a chemical element known as radium, which is later shown to be an effective treatment for cancer in small doses. This discovery continues to serve as the basis of modern radiation treatment used today.

1949
First Chemotherapy Approved by the FDA
Nitrogen mustard (mechlorethamine) becomes the first chemotherapy approved by the FDA. Chemotherapies eventually become a standard of care therapy in numerous tumor types, and continue to be an important part of cancer treatment for many patients today.

1952 - 1980
New Cancer Treatments Approved by the FDA
Advances in cancer research drive a wave of new cancer drug approvals, with more than 20 new therapies launched over the next three decades.


1953
The First Complete Cure of a Human Solid Tumor
National Cancer Institute researchers Roy Hertz and Min Chiu Li are the first to completely cure a human solid tumor with chemotherapy.
1956
First Successful Bone Marrow Transplant on a Leukemia Patient
E. Donnall Thomas, who would come to be known as the “Father of Bone Marrow Transplantation,” performs the first successful allogeneic bone marrow transplantation in a leukemia patient by harvesting bone marrow from a healthy twin for the twin who had leukemia. In 1990, Dr. Thomas would be awarded the Nobel Prize for Physiology or Medicine for this and subsequent work.


1956
First Successful Bone Marrow Transplant on a Leukemia Patient
E. Donnall Thomas, who would come to be known as the “Father of Bone Marrow Transplantation,” performs the first successful allogeneic bone marrow transplantation in a leukemia patient by harvesting bone marrow from a healthy twin for the twin who had leukemia. In 1990, Dr. Thomas would be awarded the Nobel Prize for Physiology or Medicine for this and subsequent work.


1957
Theory of Immune Surveillance Proposed
Macfarlane Burnet first describes the modern theory of immunotherapy, finding that cancer cells are recognized by the immune system, but acquired tolerance prevents clearance in patients with cancer.

1964
First Application of Combination Chemotherapy
Emil Frei and Emil Freireich give a combination of chemotherapy treatments to children with leukemia, which leads to curative therapies for acute childhood leukemia, Hodgkin’s disease and germ cell cancers.


1971
Nixon Declares War on Cancer
President Richard Nixon signs the National Cancer Act, declaring war on cancer. The law strengthens the National Cancer Institute and increases its budgetary authority.
1975
Creation of Monoclonal Antibodies
César Milstein and Georges Köhler publish a report in Nature describing how they successfully produced large amounts of monoclonal antibodies targeted to recognize the same antigen. This method would revolutionize the treatment landscape and pave the way for a vast number of clinical and research applications.


1975
Creation of Monoclonal Antibodies
César Milstein and Georges Köhler publish a report in Nature describing how they successfully produced large amounts of monoclonal antibodies targeted to recognize the same antigen. This method would revolutionize the treatment landscape and pave the way for a vast number of clinical and research applications.


1984
First Patient Dosed With IL-2 Therapy
A 33-year-old woman with metastatic melanoma receives an infusion of recombinant IL-2. After a few months, all evidence of cancer is gone. This is the first time a purely immunologic maneuver is used to mediate the destruction of large, invasive cancers in humans. The IL-2 therapy is eventually approved by the FDA in 1992.

1970s - 1988
Ubiquitin Proteasome Pathway Characterized, Role in Protein Degradation Identified
In a series of studies in the late 1970s and early 1980s, investigating how proteins degrade in cells, Avram Hershko, Aaron Ciechanover, and Irwin A. Rose discover and characterize the adenosine triphosphate (ATP)-dependent, ubiquitin-mediated protein degradation system. As a result of their pioneering studies, they would be awarded the 2004 Nobel Prize in Chemistry for the discovery of ubiquitin-mediated protein degradation.


1986
First Approved Immunotherapy Drug for Advanced Cancer
The FDA approves the first immunotherapy drug, alfa-interferon, to treat rare, hairy cell leukemia.
1987
HER-2 Gene Shown to be Amplified in Breast Cancer
Cancer researchers discover that the growth receptor gene HER-2 is present at high levels in approximately 30 percent of breast cancers. Dr. Dennis Slamon and his team discover that blocking HER-2 through a specific antibody could slow the growth of metastatic breast cancer cells and other types of cancer in a laboratory dish.


1987
HER-2 Gene Shown to be Amplified in Breast Cancer
Cancer researchers discover that the growth receptor gene HER-2 is present at high levels in approximately 30 percent of breast cancers. Dr. Dennis Slamon and his team discover that blocking HER-2 through a specific antibody could slow the growth of metastatic breast cancer cells and other types of cancer in a laboratory dish.


1991
National Cancer Institute Signs CRADA to Develop a Taxane-Based Chemotherapy
The National Cancer Institute signs a Cooperative Research and Development Agreement (CRADA) with Bristol Myers Squibb to help develop a taxane-based chemotherapy originally derived from the bark of the Pacific yew tree. The medicine is eventually approved for multiple indications, including breast, ovarian and lung cancer. Over time, taxane-based chemotherapy has become a mainstay in cancer treatment due to its unique mechanism of action.
1992
PD-1 Immune Checkpoint Receptor Discovered
Tasuku Honjo and his team of researchers at Kyoto University discover the PD-1 immune checkpoint receptor and its role in programmed cell death, helping researchers better understand its function in the immune system.
Stem Cell Research Paves the Way for Understanding Disease Biology
Irving Weissman and his research team trace the cellular development pathway from stem cells to mature blood and immune cells in humans, while identifying the steps where the process may go awry in many blood diseases and related cancers.


1992
PD-1 Immune Checkpoint Receptor Discovered
Tasuku Honjo and his team of researchers at Kyoto University discover the PD-1 immune checkpoint receptor and its role in programmed cell death, helping researchers better understand its function in the immune system.
Stem Cell Research Paves the Way for Understanding Disease Biology
Irving Weissman and his research team trace the cellular development pathway from stem cells to mature blood and immune cells in humans, while identifying the steps where the process may go awry in many blood diseases and related cancers.


1993
CAR-T Is Born
The first CAR-T cells are made by Israeli immunologist Zelig Eshhar. Eshhar and his colleagues demonstrate that CAR-T cell therapy could redirect T cell killing to foreign proteins.
Vascular Endothelial Growth Factor (VEGF) Suppresses Tumors
Napoleone Ferrara and his colleagues show that inhibiting VEGF, a protein that stimulates the growth of blood vessels, results in a dramatic suppression of tumor growth.

1995 - 1996
First U.S. CAR-T Human Trials Initiated
The first clinical trials evaluating CAR-T therapies are initiated in the United States, first in HIV infected, discordant twin pairs and later in patients with metastatic colorectal cancer.
1996
Preclinical Activity of Immune Checkpoint Inhibition Demonstrated
University of California-Berkeley scientists Dana R. Leach, Matthew F. Krummel and James P. Allison publish the first study showing it’s possible to release the brakes on a specific molecule that protects cancer from detection by the immune system. They provide the first evidence that blocking the immune checkpoint CTLA-4 may allow the body to increase the immune response against tumor cells.


1996
Preclinical Activity of Immune Checkpoint Inhibition Demonstrated
University of California-Berkeley scientists Dana R. Leach, Matthew F. Krummel and James P. Allison publish the first study showing it’s possible to release the brakes on a specific molecule that protects cancer from detection by the immune system. They provide the first evidence that blocking the immune checkpoint CTLA-4 may allow the body to increase the immune response against tumor cells.


1997
First Monoclonal Antibody Treatment Approved by the FDA
The FDA approves the first monoclonal antibody treatment for use in patients with treatment-resistant, low-grade or follicular B-cell non-Hodgkin lymphoma. The treatment is later approved for other hematological cancers such as chronic lymphocytic leukemia and diffuse large B-cell lymphoma and paves the way for additional research that would lead to the discovery of additional monoclonal antibodies used in various types of cancer treatment.
1998
First Tyrosine Kinase Inhibitor Clinical Trial
Biochemist Nicholas Lyndon develops the first tyrosine kinase inhibitor. Tyrosine kinases are important mediators of biological processes and the deregulation of protein kinase activity is discovered to play a central role in the development of cancer. This research leads to a deep understanding of disease biology, including the role of the BCR-ABL fusion gene and Philadelphia chromosome in the development of leukemia.
The first tyrosine kinase inhibitor is approved by the FDA in 2001 and is nicknamed the “magic bullet” as a result of its impact on the treatment of chronic myeloid leukemia.
Clinical Trials See Success Targeting HER-2
Phase 3 trials of a HER-2-specific antibody have positive results in slowing the growth of breast cancer and early-stage HER-2 positive metastatic breast cancer.


1998
First Tyrosine Kinase Inhibitor Clinical Trial
Biochemist Nicholas Lyndon develops the first tyrosine kinase inhibitor. Tyrosine kinases are important mediators of biological processes and the deregulation of protein kinase activity is discovered to play a central role in the development of cancer. This research leads to a deep understanding of disease biology, including the role of the BCR-ABL fusion gene and Philadelphia chromosome in the development of leukemia.
The first tyrosine kinase inhibitor is approved by the FDA in 2001 and is nicknamed the “magic bullet” as a result of its impact on the treatment of chronic myeloid leukemia.
Clinical Trials See Success Targeting HER-2
Phase 3 trials of a HER-2-specific antibody have positive results in slowing the growth of breast cancer and early-stage HER-2 positive metastatic breast cancer.

1999
First Anti-CTLA-4 Antibody Is Discovered
While at Medarex, scientists Alan Korman and Nils Lonberg discover the first anti-CTLA-4 antibody (or CTLA-4 inhibitor), based on the work of James Allison as well as Dr. Lonberg’s genetically engineered “transgenic mice” that have human antibody genes. The CTLA-4 inhibitor enters the clinic in 2000.


2000
First Antibody-Drug Conjugate Approved by the FDA
The FDA approves the first antibody-drug conjugate for the treatment of patients with newly diagnosed acute myeloid leukemia.
2001
First Molecularly Targeted Treatment Approved
The FDA approves the first molecularly targeted drug for the treatment of patients with chronic myelogenous leukemia.

2001
First Molecularly Targeted Treatment Approved
The FDA approves the first molecularly targeted drug for the treatment of patients with chronic myelogenous leukemia.


2002
PD-1 Implicated in Tumor Immune Escape
Researchers from the Japan Science and Technology Corporation and Kyoto University publish a landmark paper in the Proceedings of the National Academy of Sciences, which identifies the PD-1 pathway as a key mechanism in tumor immune escape.
2003
The Human Genome Project Concludes
The Human Genome Project, the world’s largest collaborative biological project, concludes its 13-year program determining the sequence of chemical base pairs that make up human DNA and mapping the human genome. This research continues to help scientists identify genetic changes and malfunctions that contribute to cancer.
FDA Approves First Proteasome Inhibitor
The FDA approved the first proteasome inhibitor for patients with multiple myeloma. This approval helped spur research into other applications of proteasome inhibitors, including inhibitors against specific E3 ligases, which act at an early step in the ubiquitin proteasome system, known to play a fundamental role in protein degradation.


2003
The Human Genome Project Concludes
The Human Genome Project, the world’s largest collaborative biological project, concludes its 13-year program determining the sequence of chemical base pairs that make up human DNA and mapping the human genome. This research continues to help scientists identify genetic changes and malfunctions that contribute to cancer.
FDA Approves First Proteasome Inhibitor
The FDA approved the first proteasome inhibitor for patients with multiple myeloma. This approval helped spur research into other applications of proteasome inhibitors, including inhibitors against specific E3 ligases, which act at an early step in the ubiquitin proteasome system, known to play a fundamental role in protein degradation.


2004
EGFR Mutation Associated With Response to Therapy
A team of researchers at Massachusetts General Hospital generates a breakthrough discovery, confirming the EGFR mutation is associated with response to tyrosine kinase inhibitors in non-small cell lung cancer patients. This discovery spurs a new wave of targeted cancer treatments and is often credited with the birth of precision medicine.
First VEGF-Inhibitor Receives FDA Approval for Colon Cancer
Following successful Phase 3 trials of 925 untreated metastatic colon cancer patients, the first VEGF-inhibitor is approved by the FDA.
2005
The Cancer Genome Atlas Launches
The Cancer Genome Atlas (TCGA), a collaboration between the National Cancer Institute (NCI) and the National Human Genome Research Institute (NHGRI), is initiated to map out key genomic changes in 33 different tumor types. Over the course of 12 years, the project generates more than 2.5 petabytes of data which benefits thousands of researchers in the fight against cancer.


2005
The Cancer Genome Atlas Launches
The Cancer Genome Atlas (TCGA), a collaboration between the National Cancer Institute (NCI) and the National Human Genome Research Institute (NHGRI), is initiated to map out key genomic changes in 33 different tumor types. Over the course of 12 years, the project generates more than 2.5 petabytes of data which benefits thousands of researchers in the fight against cancer.


2006
Approval of First IMiD® Agent Shown to Have Activity in Multiple Myeloma
In May 2006, the FDA approves the first immunomodulatory imide drug (IMiD agent) shown to have activity in multiple myeloma. This was also the first treatment to target the ubiquitin proteasome system, an important process in protein degradation. The drug’s approach would lead the way for the development of future IMiD agents for the treatment of multiple myeloma, which would become standards of care, and drive research exploring how to leverage protein homeostasis in other disease areas.

2010
PD-L1 Identified as a Biomarker of Response to Anti-PD-1 Therapy
An early clinical study evaluating PD-1 inhibition provides the first piece of evidence that expression of PD-L1 (a cell surface protein involved in immune response) may be a predictive biomarker of response to I-O therapy. This finding is later validated in subsequent studies.


2011
First Approved CTLA-4 Inhibitor
In March 2011, the FDA approves the first anti-CTLA-4 therapy in the United States. The approval encourages further study of I-O treatments and drives more than one thousand clinical trials in the years that follow.
2012
CAR-T Therapy Shows Promise in Cancer Treatment
Emma Whitehead, a six-year-old with acute lymphoblastic leukemia, receives an experimental treatment that used a disabled form of the HIV virus to reset the immune system to kill cancer cells genetically. The successful treatment helped to launch the explosion of CAR-T development.


2012
CAR-T Therapy Shows Promise in Cancer Treatment
Emma Whitehead, a six-year-old with acute lymphoblastic leukemia, receives an experimental treatment that used a disabled form of the HIV virus to reset the immune system to kill cancer cells genetically. The successful treatment helped to launch the explosion of CAR-T development.


2013
Initiation of I-O/I-O Combination Clinical Trials
Initiation of the first late-stage I-O/I-O combination clinical trials combining a CTLA-4 inhibitor with a PD-1 inhibitor. This trial contributes to the approval of the first I-O/I-O combination treatment in 2015.
Cancer Immunotherapy Named “Breakthrough of the Year”
Science Magazine names cancer immunotherapy as the “Breakthrough of the Year” following a period of significant advancement in I-O research.
2014
First Approved PD-1 Inhibitors
Following the approval of the first anti-CTLA-4 therapy three years earlier, the first anti-PD-1 therapies are approved by the FDA. Today, there are five FDA-approved anti-PD-1 (or anti-PD-L1) therapies approved to treat patients.
First Approved Bi-Specific T-Cell Engager
In December 2014, the FDA approves the first bi-specific T-cell engager for Philadelphia chromosome-negative relapsed or refractory B-cell precursor acute lymphoblastic leukemia in adults and children.


2014
First Approved PD-1 Inhibitors
Following the approval of the first anti-CTLA-4 therapy three years earlier, the first anti-PD-1 therapies are approved by the FDA. Today, there are five FDA-approved anti-PD-1 (or anti-PD-L1) therapies approved to treat patients.
First Approved Bi-Specific T-Cell Engager
In December 2014, the FDA approves the first bi-specific T-cell engager for Philadelphia chromosome-negative relapsed or refractory B-cell precursor acute lymphoblastic leukemia in adults and children.


2016
CAR-T Cells Show Promise in Blood Cancers
Multiple clinical trials show CAR-T cell therapy has promising results in treating patients with relapsed or refractory B cell malignancies, including acute and chronic lymphocytic leukemia, which typically all have a poor prognosis despite the use of aggressive therapies.
2017
FDA Approves First Therapy Based on Tumor Agnostic Genetic Information
The FDA approves the first therapy based on a patient’s tumor’s genetic information, rather than the type or location of the tumor within the body.
FDA Approves First CAR-T Therapy
The first CAR-T therapy is approved in 2017 for the treatment of young adult and pediatric patients with B-cell precursor acute lymphoblastic leukemia.


2017
FDA Approves First Therapy Based on Tumor Agnostic Genetic Information
The FDA approves the first therapy based on a patient’s tumor’s genetic information, rather than the type or location of the tumor within the body.
FDA Approves First CAR-T Therapy
The first CAR-T therapy is approved in 2017 for the treatment of young adult and pediatric patients with B-cell precursor acute lymphoblastic leukemia.


2018
Nobel Prize Awarded for Immuno-Oncology Discoveries
James Allison and Tasuku Honjo are awarded the 2018 Nobel Prize in Physiology or Medicine for their discoveries that led to the development of I-O therapies.

2019
First KRAS Inhibitors Show Promise
Results from early studies indicate potential in targeting KRAS mutations, which are found in up to 25 percent of all cancers and which researchers had considered “undruggable” for the past 30 years.

Today
Advances Continue in the Scientific Discovery of New Cancer Treatments
Uncovering Insights to Inform Drug Discovery:
The scientific community is working to answer key questions in critical areas of drug discovery, and in turn, generate better hypotheses and clinical trials that help drive efficient clinical development.
Embracing Technology for Cancer Research:
Modern technology has finally caught up with complex science, allowing for multifaceted data-driven analyses. This technology can produce information at a rapid rate and help answer some of the most complex questions in cancer research as scientists work to improve patient care.
Exploring Novel Oncology Approaches:
Informed by a deeper understanding of cancer biology, scientists are leveraging diverse modalities and novel targets to evaluate new ways to activate an anti-tumor immune response in more patients, including those who might be resistant to current treatments.
Developing Precision Approaches:
The scientific community is committed to helping find the right treatment for the right patient at the right time. Researchers are working with urgency to identify genetic markers which may help inform the best treatment approach for patients.

Tomorrow
While we have come so far in the fight against cancer, in many ways we’re also just at the beginning. We are pursuing new therapies at the forefront of scientific innovation by advancing research into cell therapy, immuno-oncology and protein homeostasis and more novel platforms. Through additional validation, continued research into existing therapies, the exploration of novel combinations and the application of translational medicine, the goal of leveraging biological insights to drive precision medicine for patients is reachable. And we will not stop until more and more patients are able to prevail over cancer and other serious diseases.